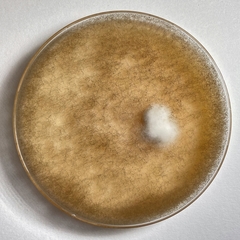
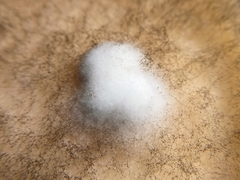
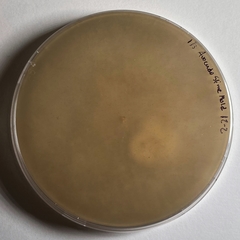

Botrytis: taxon details and analytics
- Domain
- Kingdom
- Fungi
- Phylum
- Ascomycota
- Class
- Leotiomycetes
- Order
- Helotiales
- Family
- Sclerotiniaceae
- Genus
- Botrytis
- Species
- Scientific Name
- Botrytis
Summary description from Wikipedia:
Botrytis (fungus)
Botrytis is a genus of anamorphic fungi in the family Sclerotiniaceae. Botrytis (also known as grey mold) belongs to the group hyphomycetes and has about 30 different species. It is a plant parasite as well as saprophytes on both agricultural and forest trees. It produces stout, dark, branching conidiophores that bear clusters of paler conidia (grey in mass) on denticles from apical ampullae. It is a common outdoor fungus and can be detected in spore trap samples. The fungus is often found growing on indoor plants. Although no mycotoxin has been reported from this fungus, it may cause hay fever, asthma and keratomycosis. The most common species is B. cinerea, which is a plant pathogen causing gray mould on a very broad range of hosts including some common ornamental plants, such as geranium, begonia, rose, lily, dogwood, rhododendron, dahlia, magnolia, camellia and fruits and produce. This fungus is mainly of outdoor origin, although it may be from growth on fruits or flowers brought in from outdoors. Some houseplants can be infected by this fungus, such as cyclamen, poinsettia, chrysanthemum, and gerbera. Other species of Botrytis may be present, such as B. peoniae on peonies, B. squamosa on onion, and B. tulipae on tulips. These species of Botrytis share some common characteristics in pathology and ecology.
The generic name Botrytis is derived from the Greek bótrys ("cluster of", "grapes") and the Latin suffix -itis ("like").
...Botrytis in languages:
- Lithuanian
- Kekeras
Images from inaturalist.org observations:
We recommend you sign up for this excellent, free service.
Parent Taxon
Sibling Taxa
Child Taxa
- Botryotinia calthae
- Botryotinia convoluta
- Botryotinia ficariae
- Botryotinia ranunculi
- Botrytis aclada
- Botrytis allii
- Botrytis anthophila
- Botrytis atrofumosa
- Botrytis aurantiaca
- Botrytis bifurcata
- Botrytis byssoidea
- Botrytis capsularum
- Botrytis cinerea
- Botrytis convallariae
- Botrytis densa
- Botrytis elliptica
- Botrytis epigaea
- Botrytis fabae
- Botrytis fuliginosa
- Botrytis galanthina
- Botrytis gladioli
- Botrytis gladiolorum
- Botrytis latebricola
- Botrytis minutula
- Botrytis paeoniae
- Botrytis pannosa
- Botrytis pellicula
- Botrytis porri
- Botrytis pseudocinerea
- Botrytis sphaerosperma
- Botrytis squamosa
- Botrytis tulipae
- Botrytis umbellata